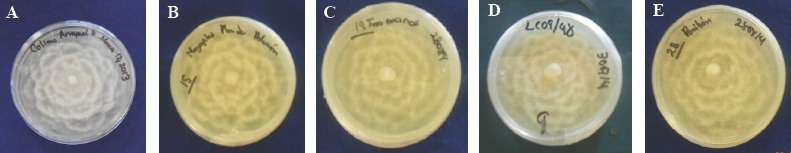

Phytophthora cinnamomi es un microorganismo del suelo que provoca grandes pérdidas económicas y daños ecológicos; causante de pudriciones radicales, cuello, tronco y ramas. Afecta a muchas especies de plantas en la agricultura, horticultura y especies forestales, que incluye a más de 1000 especies y cuenta con una amplia distribución geográfica, en todo el mundo (Crone et al., 2013; Erwin y Ribeiro, 1996; Garbelotto et al., 2006; Philip et al., 2009; Zentmyer, 1980). La primera descripción de Phytophthora cinnamomi la realizó Rands, en 1922, como el agente causal del cancro en tallo de árboles de canelo, en Sumatra (Erwin y Ribeiro, 1996). Desde entonces sus daños se han reportado en diferentes hospedantes. En México, los primeros reportes de P. cinnamomi fueron realizados por Zentmyer en 1952, causando daños severos en áreas productoras de aguacate y pérdidas de hasta 90 % (Pérez, 2008; Téliz y Mora, 2007; Tamayo, 2007). Así mismo, se ha reportado en bosques naturales de Quercus spp, a principios del año 2000, en El Arrayanal, Col., ocasionando la muerte y daños en árboles de encino (Tainter et al., 2000). Posteriormente se le encontró afectando árboles del mismo género en la Reserva de la Biosfera, en Jalisco (Davidson et al., 2003) y en Tecoanapa, Gro. (Alvarado et al., 2007 y 2008).
También se reporta que afecta árboles de Pseudotsuga menziesii en los estados de Jalisco, Edo. de México y Veracruz (García, 2007). Los síntomas causados por el patógeno son clorosis, defoliación, muerte de ramas, cancros en la corteza y pudrición de raíz, lo que ocasiona la muerte del árbol (Dos Santos et al., 2011; Erwin y Ribeiro, 1996). La patogenicidad del género de Phytophthora, está influenciada por condiciones de temperatura, precipitación, humedad, textura del suelo, pH y disponibilidad de nutrientes (Shew y Benson, 1983; Balci et al., 2008; Jonsson et al., 2005; Sánchez et al., 2005; Thompson et al., 2014). La patogenicidad depende del tipo de cepa y adaptación de los patógenos en la planta, y puede ser estimada por la rapidez del patógeno en dañar al hospedante (Pariaud et al., 2009; Robin and Desprez., 1998)
En México se han realizado pruebas de patogenicidad de P. cinnamomi en variedades de aguacate, sin embargo, no hay reportes de estas con aislados de P. cinnamomi procedentes de distintas regiones de México, obtenidas de especies forestales. Este patógeno representa una amenaza para especies de plantas tanto comerciales como bosques naturales, que se encuentran en otras partes del país, ya que el desconocimiento de esta información puede traer como consecuencia una importancia económica y ecológica de la especie afectada. La identificación de este patógeno ha sido a través del uso de claves taxonómicas, medios selectivos y muy recientemente se ha caracterizado empleando diferentes técnicas moleculares mediante PCR (Polymerase Chain Reaction), con iniciadores específicos para cada especie obteniendo resultados importantes sobre la taxonomía, filogenia y variabilidad del hongo (Gallegly y Hong, 2008; Tsai et al., 2006; Martín et al., 2000). Por lo anterior, el objetivo de este estudio fue identificar y evaluar la patogenicidad de cinco aislados de P. cinnamomi, procedentes de cinco regiones de México obtenidos de árboles de Quercus elliptica, Q salicifolia, Q. peduncularis, Pseudotsuga mensiezii y Persea americana., en plantas de P. mensiezii.
Materiales y métodos
Aislamiento del patógeno
Los aislados empleados en esta investigación se obtuvieron de suelo, raíz o cancros de árboles de Quercus salicifolia, de El Arrayanal, Col. (COL-A); Quercus elliptica de Tecoanapa, Gro. (GRO-P), Quercus peduncularis de Manantlán, Jal. (JAL-C), Pseudotsuga mensiezii del Edo. de México (EDO-T) y Persea americana, de Peribán Mich. (MICH-P), los cuales fueron identificados a través de un análisis morfológico a género y molecular a especie.
Los árboles mostraban síntomas característicos que causa P. cinnamomi, entre estos muerte regresiva, marchitez, clorosis, defoliación prematura, cancros y exudado color oscuro en la corteza. Para obtener al patógeno directamente en campo, a partir de cancros, se utilizó medio selectivo PARPH (pimaricina-ampicilina-rifampicina-PCNB e himexazol) (Jeffer y Martín, 1986; Erwin y Ribeiro, 1996. En laboratorio las muestras de raíz, se desinfectaron y sembraron en medio selectivo PARPH. Para las muestras colectadas de suelo, se utilizó un método de trampeo con discos de camelia, una suspensión de agua suelo + raíz y medio selectivo (Almaraz et al., 2013). El aislado de aguacate, fue proporcionado por el Dr. Salvador Ochoa Ascencio de la Facultad de Agrobiología "Presidente Juárez" de la UMSNH. El aislado de planta de aguacate se obtuvo por los síntomas característicos de la enfermedad tristeza del aguacatero por P. cinnamomi.
Identificación morfológica
Las colonias obtenidas de Phytophthora se les realizó punta de hifa y se transfirieron a cajas Petri con medio de cultivo PDA (papa-dextrosa-agar) y se incubaron durante siete días en oscuridad, a una temperatura de ± 25 °C (Zentmyer, 1980). Posteriormente se caracterizaron a género con base en la morfología de la colonia y estructuras de reproducción. El desarrollo de las colonias se midió diariamente de cada uno de los aislamientos, hasta que el oomyceto llenó la caja Petri. Para la producción de esporangios se realizó una suspensión de extracto de suelo + agua destilada estéril, en la cual se colocó discos de micelios de 5 mm de diámetro en cajas Petri (Romero, 1996), estas cajas se colocaron a una temperatura de ± 25 °C bajo condiciones de luz continua por seis días. Los esporangios se observaron al microscopio y se realizaron las descripciones de cada aislamiento así como sus mediciones de la relación largo y ancho, se midieron 100 esporangios de cada aislamiento.
Una vez identificados a género todos los aislamientos, se procedió a conservarlos en tubos de ensayo que contenían PDA agregando aceite mineral. Todo esto se realizó en el laboratorio de Patología Forestal del Colegio de Postgraduados.
Caracterización molecular
El ADN de cada aislamiento que se utilizó para la identificación a especie se extrajo de colonias miceliales desarrolladas en medio de cultivo PDA de aproximadamente siete días de crecimiento. Para la extracción del ADN se empleó la técnica de Sambrook y Russell (2001). El ADN total obtenido se visualizó por electroforesis en gel de agarosa al 0.8 % y se cuantificó en un espectrofotómetro Nanodrop 1000 (Termoscientific).
PCR. Para realizar el análisis por PCR del ADN extraído, se amplificaron las regiones ITS con los primers ITS'5 (GGAAGTAAAAGTCGTAACAAGG) e ITS'4 (TCCTCCGCTTATTGATATGC) de genes rRNA de las subunidades 18S-5.8S y 5.8S-28S (White et al., 1990). Para la reacción de PCR se utilizó un volumen final de 25 μL con la siguiente formulación: 13.22 μL de agua ultrapura estéril, 2.5μL con solución amortiguadora de buffer 5X, 2.08 μL de MgCl2 a 2.5 mM, 2 μL dNTPs a 2.0 mM, 2 μL de cada primers a 20 ρMol, 0.2 μL de Taq-DNA polimerasa a 1.5 U y 1 μL de muestra de ADN 80 ng. La amplificación de los iniciadores se realizó en un termociclador Perkin-Elmer (Mod. CT 2400), con el siguiente programa: un ciclo inicial de desnaturalización del ADN a 95 °C por 2 min; 30 ciclos a 95 °C por 1 min, alineación a 50 °C por 30 s y extensión a 72 °C por 2 min; la extensión final fue a 72 °C por 10 min. El fragmento amplificado se purificó con el KIT Quiagen® y la calidad se verificó por electroforesis en gel de agarosa al 1 % teñido con bromuro de etidio. La banda se visualizó en un transiluminador (GelDoc 2000, BIO RAD®), y se analizó con el programa Quantity One 4.0.3 (Sambrook y Russel, 2001). El producto de PCR se envió a la compañía Macrogen, E.U.A, para su secuenciación (Automatic Sequencer 3700xl DNA Analyzer).
Las secuencias obtenidas con los iniciadores ITS5-ITS4 se alinearon con las disponibles en el banco de genes del Nacional Center for Biotechnology Information (NCBI), de E.U.A. (http://www.ncbi.nlm.nih.gov). De los valores cuantitativos generados, solo se bajaron las secuencias con el valor más alto, para su comparación con las que se obtuvieron en este estudio. Las secuencias se alinearon con Clustal W versión 1.6. y se depositaron en la base de datos del Gen Bank para obtener su número de acceso.
Pruebas de patogenicidad
Una vez desarrolladas las colonias en medio de cultivo PDA con siete días de edad, se procedió a realizar las pruebas de patogenicidad. De cada uno de los aislamientos obtenidos se procedió a realizar las pruebas bajo condiciones de invernadero en árboles cultivados en macetas de Pseudotsuga menziesii de tres años de edad, con una altura de 45 a 47 cm. La inoculación se realizó con el método de disco de micelio en tallo (O'Gara et al., 1996). En el punto de inoculación los tallos de plantas se limpiaron con agua destilada estéril, con una aguja de disección desinfectada con alcohol al 70 % y flameada al mechero, se realizaron 10 punciones, de cada aislado se tomaron discos de 0.5 mm de diámetro con micelio del pseudohongo crecido en medio de cultivo PDA, los cuales se colocaron en el área y se cubrieron con algodón estéril húmedo, y se cubrió con una gasa y cinta de parafilm alrededor del tallo, con el fin de mantener la humedad. Todo esto se realizó bajo condiciones asépticas.
Se inocularon cinco plantas para cada uno de los aislamientos (repeticiones), así mismo, se contó con un testigo, al que sólo se le aplicó medio de cultivo PDA, dando un total de 30 plantas inoculadas. Finalmente, a cada planta se le cubrió con una bolsa de plástico, para generar condiciones de alta humedad relativa. Así permanecieron por una semana y se mantuvieron a una temperatura ambiente ± 25 °C. Las plantas se distribuyeron al azar sobre mesas en el invernadero y se regaron cada tercer día a capacidad de campo. Se evaluó el número de días a la aparición de los síntomas y muerte en la planta, esto se realizó semanalmente durante ocho meses, y los resultados obtenidos se sometieron a un análisis estadístico (prueba de Kruskall-Wallis) utilizando el programa SAS (SAS, 2012) para determinar el comportamiento de los aislados de P. cinnamomi.
Resultados y Discusión
Los aislamientos obtenidos de suelo, raíz y cancros de árboles de las diferentes localidades se muestran en el Cuadro 1.
Cuadro 1 Aislados obtenidos de P. cinnamomi, empleados en las pruebas de patogenicidad en plantas de Pseudotsuga menziesii.
Clave | Localidad | Hospedante | Origen Suelo/Raíz/cancro |
---|---|---|---|
COL - A | El Arrayanal, Col. | Quercus salicifolia. | cancro |
GRO - P | Tecoanapa, Gro | Quercus elliptica. | cancro |
JAL - C | Manantlán, Jal. | Quercus peduncularis. | Suelo |
MICH- P | Peribán, Mich. | Aguacate | Raíz |
EDO -T | Tres Encinos. Edo. de México | Pseudotsuga menziesii | Suelo |
Identificación morfológica
Las cinco colonias aisladas de árboles de Q. salicifolia, Q. elliptica, Q. peduncularis, Pseudotsuga mensiezii y Persea americana mostraron un crecimiento uniforme en medio de cultivo PDA observándose el crecimiento micelial de aspecto algodonoso, de color blanco, en forma de camelia (Figura 1) debido al crecimiento deprimido; micelio cenocítico, toruloso, con hifas coraloides y abundantes hinchamientos, todo esto a nivel de género. Se observó que este patógeno produce clamidosporas esféricas, ovales, piriformes, terminales o intercalares, frecuentemente en racimos, algunos autores mencionan que persisten en el suelo por años, las cuales constituyen un órgano de conservación y supervivencia como lo reportan Erwin y Ribeiro (1996); Jung et al., (2013) y Zentmyer et al., (1996).
Figura 1 A) Colonias de los aislados heterotálicos de P. cinnamomi de seis días con clave: A) COL-A y siete días de edad con clave: B) GRO-P, C) EDO-T encinos, D) JAL-C y E) MICH-P en forma de camelia desarrollándose en medio de cultivo PDA.
Además, se midió el largo y ancho promedio de 100 esporangios de cada aislamiento, éstos fueron los siguientes: COL-A 40.49 x 28.19, JAL-C 40.81 x 28.63 μm, GRO-P 48.24 x 31.47 μm, EDO-T 43.2 x 32.9 μm y MICH 56.23 x 33.8 μm, por su parte Erwin y Ribeiro (1996), reportan valores de 75 x 40 μm, por lo que no concuerdan con las obtenidas en este estudio. En cuanto al tamaño de los esporangios, estos varían con las condiciones ambientales y solo se producen en extracto de suelo (Sánchez et al., 2002b). En las características morfológicas de los esporangios de P. cinnamomi, ovoides a elongados y ápice no papilado, concuerdan con las reportadas por Erwin y Ribeiro (1996), Gallegly y Hong (2008) y Waterhouse (1963).
Caracterización molecular
La banda del producto de PCR fue de aproximadamente 1200 a 1500 pb (Figura 3). Los resultados de la secuenciación de cada aislado se compararon con las secuencias reportadas en el banco de genes (NCBI). Las secuencias por aislamiento tuvieron 99 % de índice de similaridad para la especie P. cinnamomi. Al comparar los nucleótidos de cada aislamiento e identificados morfológicamente con las reportadas en el banco de genes (NCBI), estas correspondieron a la misma especie. Esto corroboró la identificación morfológica de cada aislado (Cuadro 3).

Figura 2 A) Desarrollo de síntomas en plantas de Pseudotsuga menziesii de tres años de edad inoculadas con los diferentes aislados de P. cinnamomi clave (COL-A, GRO-P, EDO-T, JAL-C, y MICH-P). B) Cancro en plantas. C) Resinación en la base del tallo. D) Progreso de la enfermedad en la planta E) Cancro de coloración café claro a oscuro causado por el aislamiento COL-A. F) Testigo y plantas inoculadas durante las pruebas de patogenicidad. G) Tejido enfermo del aislado COL-A y micelio del organismo en medio selectivo PARHP. H) Reaislamiento COL-A de P. cinnamomi de siete días en PDA.

Figura 3 Electroforesis en gel de agarosa al 1 % que muestra una banda de aproximadamente 1500 pb del producto amplificado por PCR con los iniciadores ITS4 e ITS5; M. Marcador molecular de 1 kb, carril 1. COL-A., 2. GRO-P., 3. JAL-C., 4. MICH-P y 5. EDO-T.
Cuadro 2 Prueba de Kruskal-Wallis para evaluar número de días en síntomas y la muerte en las plantas inoculadas con los cincos aislamientos de Phytophthora cinnamomi.
Tratamiento | Hongo | Medias de rangos | Grupos |
Testigo | P. cinnamomi | 31.50 | A |
MICH-P | P. cinnamomi | 60.68 | B |
EDO-T | P. cinnamomi | 64.85 | B |
JAL-C | P. cinnamomi | 64.85 | B |
GRO-P | P. cinnamomi | 66.52 | B |
COL-A | P. cinnamomi | 97.00 | C |
Letras iguales no difieren significativamente entre tratamientos.
Cuadro 3 Identificación morfológica y molecular de aislados de Phytophthora cinnamomi, número de nucleótidos, especie alineada con el 99 % de confiabilidad y número de acceso en la base de datos del National Center for Biotecnology Information (NCBI).
Clave de Aislamiento | Identificación Morfológica | No. de nucleótidos | Especie alineada | Núm. de acceso a especie alineada NCBI |
Col-A | P. cinnamomi | 1046 | P. cinnamomi | KP773290 |
GRO-P | P. cinnamomi | 925 | P. cinnamomi | KP773291 |
JAL-C | P. cinnamomi | 940 | P. cinnamomi | KP773292 |
MICH-P | P. cinnamomi | 926 | P. cinnamomi | KP773293 |
EDO-T | P. cinnamomi | 952 | P. cinnamomi | KP773294 |
Pruebas de patogenicidad
Las plantas de Pseudotsuga mensiezii que se les colocó el patógeno empezaron a presentar síntomas de marchitez de brotes, flacidez en las puntas, clorosis en las acículas, muerte de ramas en la base de la planta. Acompañado del desarrollo de cancro en el tallo, el cual se caracterizó por la presencia de necrosis en la epidermis del mismo y desprendimiento de la corteza, dando una coloración de color café claro a oscura.
Los aislados presentaron una patogenicidad diferente en el hospedante inoculado. El aislado COL-A del Arrayanal, Col., procedente de Quercus salicifolia, fue el primero en causar síntomas visibles a los 67 ddi y la muerte de la plantas a los 120 días después de la inoculación. Además se observó que el aislamiento procedente del El Arrayanal, Col. (COL-A) fue el primero en cubrir la caja Petri a los cinco días; así mismo, el primero en la formación de esporangios en seis días en solución de suelo. El aislado GRO-P, procedente de Q. elliptica, ocasionó los síntomas 93 ddi y la muerte 180 días después de la inoculación; en el caso del EDO-T, de Pseudotsuga mensiezii, se requirieron 135 ddi lo mismo que para JAL-C, obtenido de Q. peduncularis y la muerte de la plantas 210, y para MICH-P, aislado de Persea americana 160 ddi y 240 días para la muerte (Figura 2). Los resultados anteriores muestran que todos los aislamientos fueron capaces de causar enfermedad pero el aislado COL-A se comportó como el más patogénico en las plantas de Pseudotsuga menziesii, por lo que fue evidente que hay variación de patogenicidad entre los aislamientos de P. cinnamomi de las diferentes regiones de México.
Los datos anteriores, específicamente determinan la muerte en base a patogenicidad de los aislamientos, estos resultados se sometieron a un análisis estadístico utilizando la prueba de KrusKallWallis. Se obtuvieron diferencias significativas entre los aislados (P 0.0001) (Cuadro 2). El aislado COL-A fue estadísticamente diferente al resto de los demás, mostrando una media de rango mayor a la de los otros.
A partir del tejido infectado de las plantas inoculadas con cada aislado, se re aisló el patógeno P. cinnamomi. Las plantas de Pseudotsuga menziesii que se emplearon como testigo no presentaron ningún síntoma. No se encontraron estudios similares en especies forestales, sin embargo, estos resultados concuerdan con lo obtenido por Ceja et al., (2000) en plantas de aguacate inoculadas con P. cinnamomi quienes observaron que el patógeno provocó marchitez en el follaje, presencia de cancro de color oscuro en tallo con una lesión interna de color café y finalmente la muerte de las plantas.
En este estudio se relacionó la sintomatología causada por los aislados en plantas de Pseudotsuga mensiezii, la cual coincide con lo reportado por Erwin y Ribeiro (1996).
Por otra parte, Jordan y Tainter (1996) observaron que al inocular plantas de robles blancos y rojos, estas especies son muy susceptibles a P. cinnamomi y que los síntomas pueden tardar de meses a años para ser evidentes.
De igual manera, Robin y Desprez-Loustau (1998), quienes inocularon discos de agar de micelio de P. cinnamomi en plantas de castaño y roble rojo, probaron su patogenicidad, encontrando que todas las plantas manifestaron síntomas de amarillamiento, defoliación, agrietamientos, coloración color marrón y cancros pero con diferente nivel de virulencia. Sin embargo, Chastagner (1997), hace mención que la formación o desarrollo del cancro no siempre se forma ya que este dependerá del mecanismo del patógeno y del ambiente.
Podger (1989) por su parte, menciona que cuando utilizó 14 aislados australianos de P. cinnamomi, aisladas de 10 especies de plantas hospederas, causaron enfermedad en especies de dicotiledóneas y el síntoma principal consistió de una coloración anormal en raíz y finalmente la muerte. Los aislados no mostraron diferencia en su patogenicidad.
Los resultados obtenidos en este estudio sobre la patogenicidad de los aislados de P. cinnamomi coinciden con los reportados por Huberli et al., (2001), quienes encontraron que la patogenicidad de aislados australianos en plantas de Eucalyptus marginata y Corymbia calophylla mostraron tres tipos de respuesta: la primera, con alta capacidad para matar plantas, a los 59 días, después de la inoculación; la segunda, de 182, los cuales fueron considerados intermedios y la tercera, los que no inducen muerte de planta, pero son considerados los menos patogénicos.
Por su parte, Dudzinski et al., (1993), encontraron diferencias entre los aislados de P. cinnamomi colectados en Australia inoculados en tallos de Eucalyptus marginata, estos autores detectaron una variación de la patogenicidad en la manifestación de síntomas, desde la inoculación hasta la muerte de la planta. Otros estudio realizado por Brasier et al., (1993) menciona que P. cinnamomi es un patógeno agresivo en árboles de robles y que la introducción y la propagación de suelo de bosque con el patógeno puede ser un factor importante en la declinación y disminución del alcornoques en la Península Ibérica.
Por otra parte Tippett et al., 1985. Evaluaron el método de inoculación por herida en 21 árboles de Eucalytus marginata y con un aislamiento de P. cinnamomi observaron que no existe variación en la patógenicidad de P. cinnamomi en las plantas inoculadas.
Conclusiones
Todos los aislados de Phytophthora correspondieron a P. cinnamomi y mostraron ser patogénicos sobre Pseudotsuga mensiezii de los cuales el aislado COL-A fue el más patogénico.
Este es el primer estudio en México donde se reportan la patogenicidad de aislados de P. cinnamomi procedentes de diferentes lugares y hospedantes sobre P. menziesii.